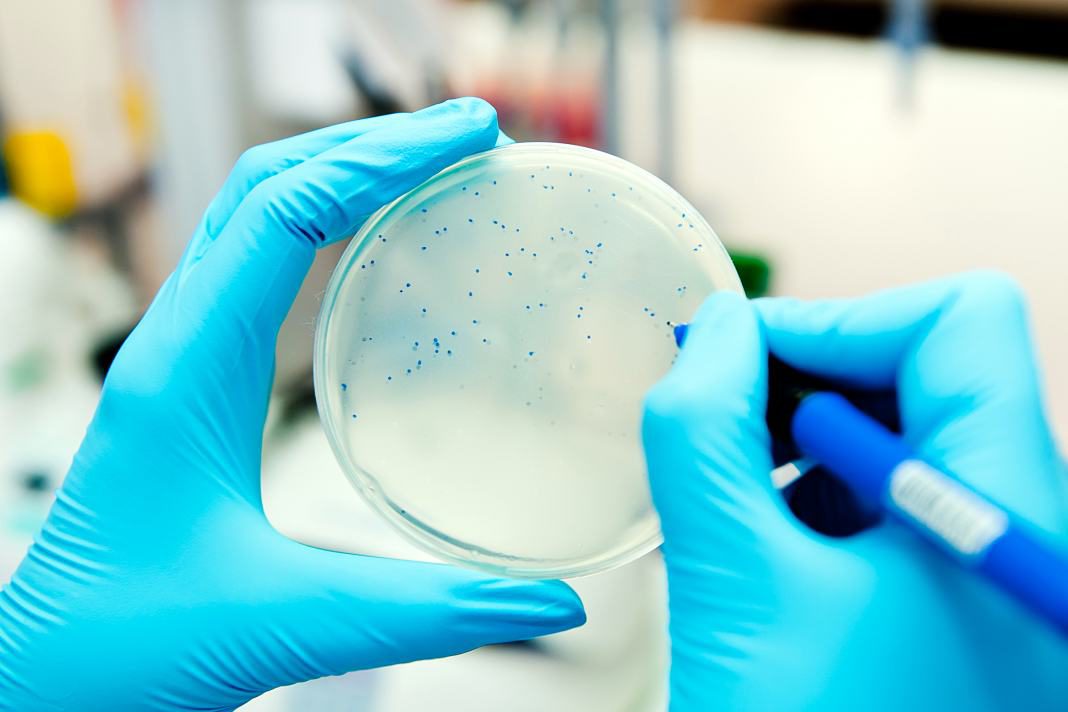

Fluconazole is an antifungal azole. It is a broad spectrum antifungal, first approved in Europe in 1988 and then in America in 1990. It was the first single dose treatment approved for vaginal candidiasis. Fluconazole is an effective agent in the treatment and prophylaxis of Candidal infection.
Trade Names:
- Diflucan* Roerig
- Diflucan* Pfizer
Dosage Types
- Oral: Tablets: Fluconazole 50, 100, 150, 200mg Diflucan*
- Capsules: Fluconazole 150mg Diflucan*
- Suspension: Fluconazole for 10mg/mL or 40 mg/mL Diflucan
- Parenteral: Fluconazole 200mg/100mL and 400mg/200mL Diflucan*
Uses:
| Labeled Indications | Off-Label Uses |
Dermatologic
| Dermatologic
|
# – not included in Canadian labeling
Therapeutic Regimen
| Adult | Pediatric |
Vulvovaginal candidiasis
Oropharyngeal candidiasis
Tinea pedis, cruris, corporis, versicolor (off label)
| Dosage has not been established for infants < 6 months old > 6 months
|
Patient Monitoring
Hepatic function tests should be monitored periodically during treatment. Transient increases in transaminases have rarely led to hepatotoxicity in patients receiving fluconazole.
Safety Information
Dose adjustment may be required in patients with renal function impairment.
Side Effects
- Cutaneous effects may include hypersensitivity reactions including exfoliative dermatitis and Stevens-Johnson syndrome.
- Gastrointestinal effects may include nausea, abdominal pain, diarrhea, constipation, loss of appetite and rarely, hepatotoxicity.
- Hematologic effects may include agranulocytosis or thrombocytopenia.
- Other effects may include headache, dizziness and drowsiness.
FDA Pregnancy Category C
Animal studies report rare fetal abnormalities. Not recommended during pregnancy or lactation.
Major Drug Interactions
Concurrent use of antidiabetic agents can lead to hypoglycemia; cyclosporine and phenytoin plasma concentrations may be increased; anticoagulant effects may be increased.
Mechanism of Action / Pharmacokinetics
Fluconazole inhibits ergosterol synthesis in the cell wall of yeast and other fungi.
In Candida albicans, fluconazole may also inhibit the transformation of blastospores into the invasive mycelial form. Fluconazole is absorbed quickly after oral administration and is widely distributed.
General References
Saag M, Dismukes WE : Azole antifungal agents : emphasis on the new triazoles. Antimicrob. Agents Chemother. 1988 : 32 : 1 – 8
Drake L, Babel D, Stewart DM, et al : Once-Weekly Fluconazole (150, 300, or 450 mg) in the Treatment of Distal Subungual Onychomycosis of the Fingernail. Jour. Am. Acad. Derm. 1998 : 38 : S87 – S94
Hay RJ, Clayton YM : Fluconazole in the management of patients with chronic mucocutaneous candidiasis. Br. Jour. Derm. 1988 : 119 : 683 – 685
Shahid J, Ihoan Z, Khan S : Oral fluconazole in the treatment of pityriasis versicolor. Jour. Derm. Treat. 2000 : 11 : 101 – 103
Shuttleworth D, Philpot CM, Knight AG : Cutaneous Cryptococcus : treatment with oral fluconazole. Br. Jour. Derm. 1989 : 120 : 683 – 687
Solomon BA, Collins R, Sharma R, et al : Fluconazole for the treatment of tinea capitis in children. Jour. Am. Acad. Derm. 1997 : 37 (2, 1) : 274 – 275
Gupta AK, Adam P, Hofstader SLR, et al : Intermittent short duration therapy with fluconazole is effective for tinea capitis. Br. Jour. Derm 1999 : 141 : 304 – 306
Scher RK, Breneman D, Rich P, et al Once-Weekly Fluconazole (150, 300, or 450mg) in the Treatment of Toenail. Jour. Am. Acad. Derm. 1998 : S77 – S86 Gupta AK, Katz HI, Shear NH : Drug interactions with itraconazole, fluconazole, and terbinafine, and their management. Jour. Am. Acad. Derm. 1999 : 41 : 237 – 249